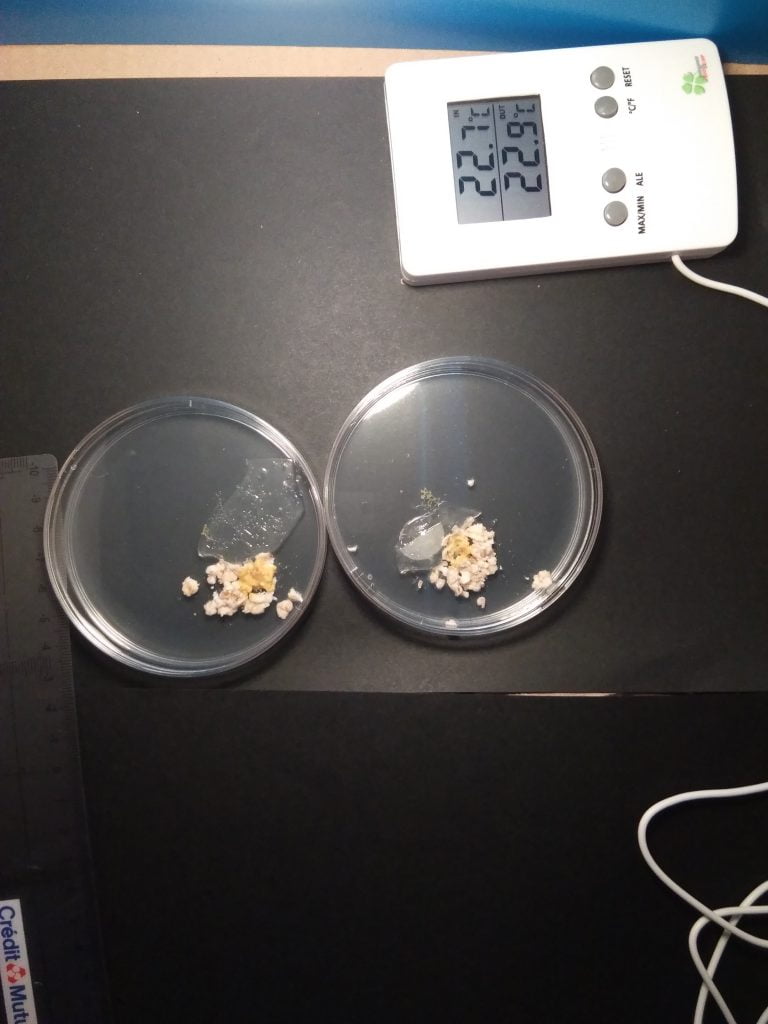
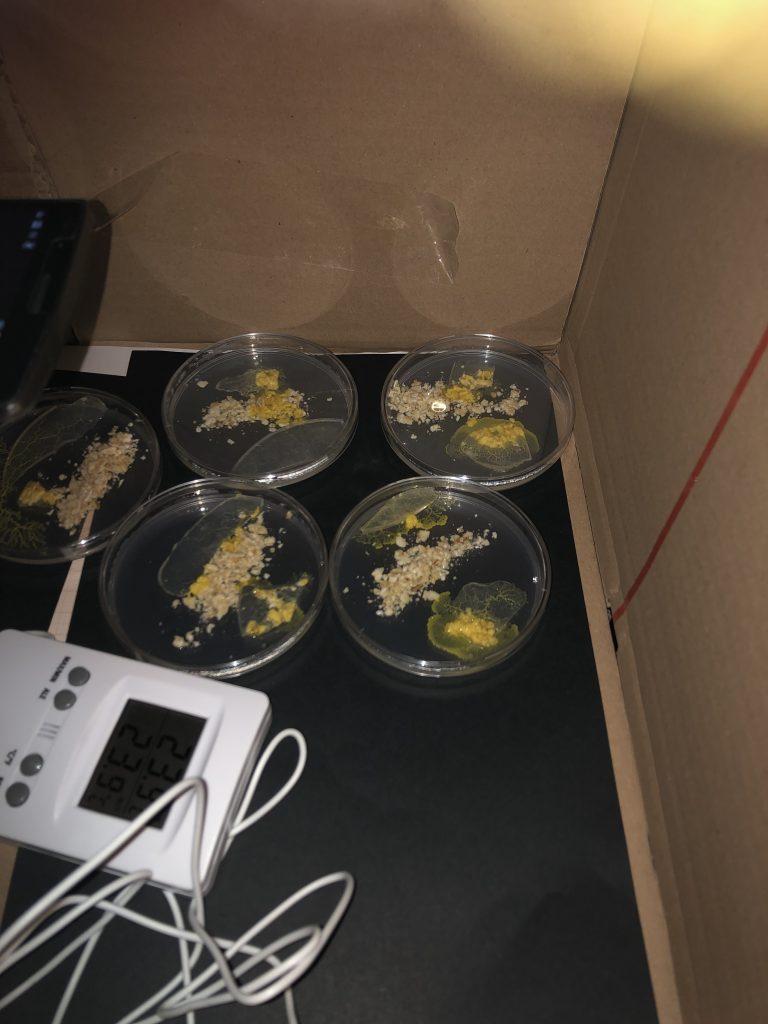

L’expérience en lien avec l’ISS se prépare : découpage et mesure du papier filtre et du blob, préparation des boîtes de pétri, fabrication de la « carton box » pour la prise de vue et test…
Voici les premières vidéos d’essai …
Les élèves ont pu également participer à l’élevage des Blob : fabrication de la gélose, mise en place d’un terrarium et début de conception de l’expérience de la cafétéria …
Dernier préparatif cette semaine avant le lancement de l’expérience par Thomas Pesquet en direct de l’ISS le mercredi 6 octobre.